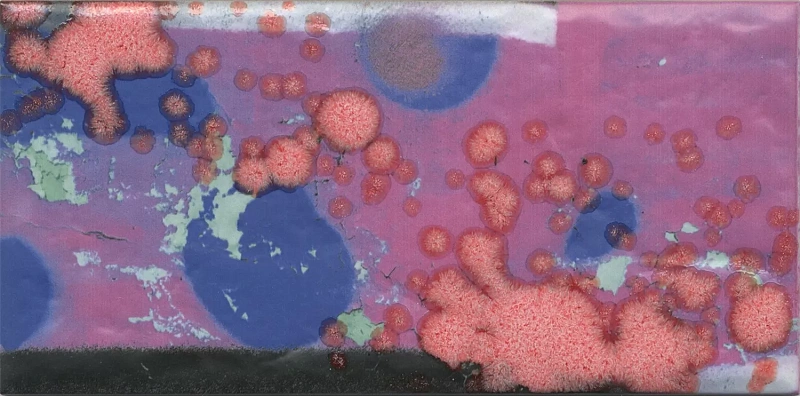
Декор Kerama Marazzi OS\A57\9x\19060 Панно Граффити 20x89,1 - фото 10

проспект, д. 32
-
Пн-Пт: 09:00-20:00;
-
Сб-Вс: 11:00-20:00
По России
+7 (800) 555-98-43
0
День
0
Час
0
Мин
0
Сек
Распродажа керамогранита, снятого с производства!
Успейте воспользоваться уникальным предложением! Товар в наличии на складе
Каталог
- Товары
- Коллекции
 Показать фильтр
Скрыть фильтр
Показать фильтр
Скрыть фильтр
5 202 

Артикул: VT\B413\4x\11037R
5 100 

Артикул: VT\A413\4x\11037R
1 336 

Артикул: VT\B162\2x\6401
1 336 

Артикул: VT\A162\2x\6397
1 871 

Артикул: HGD\A352\4x\15061
2 152 

Артикул: OS\A58\9x\19060
2 152 

Артикул: OS\A57\9x\19060
864 

Артикул: OP\A210\4x\19060